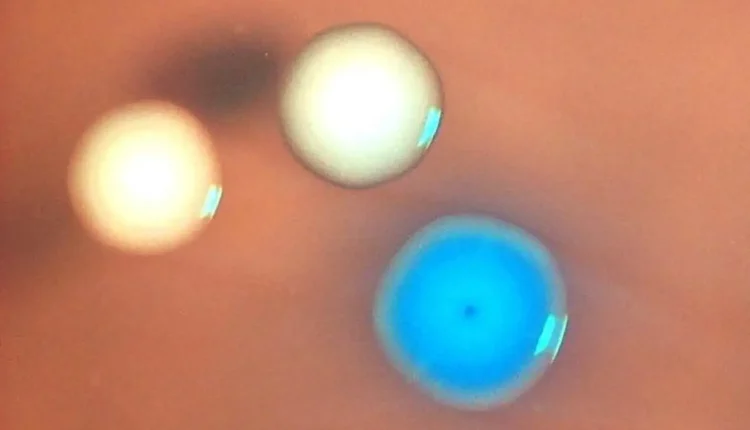

«Ζόμπι» κύτταρα δημιουργήθηκαν με μεταμόσχευση γονιδιώματος σε νεκρά βακτήρια
Ένα ζωντανό, συνθετικό κύτταρο κατασκευάστηκε μεταμοσχεύοντας ένα πλήρες γονιδίωμα σε ένα νεκρό βακτήριο, επαναφέροντάς το στη ζωή. Η ανακάλυψη θα μπορούσε να βοηθήσει τη συνθετική βιολογία να εκπληρώσει την τεράστια, αλλά ακόμα απομακρυσμένη, υπόσχεσή της να μηχανουργήσει οργανισμούς για τη δημιουργία βιώσιμων καυσίμων, φαρμακευτικών προϊόντων και νέων υλικών.
Η συνθετική βιολογία περιλαμβάνει την τροποποίηση βιολογικών συστημάτων ή τη δημιουργία νέων για την εισαγωγή καινοτόμων λειτουργιών, όπως η επανεγγραφή του DNA της μαγιάς ώστε οι οργανισμοί να παράγουν επιθυμητές χημικές ουσίες. Σε μια προσπάθεια δημιουργίας πιο ευέλικτων μηχανουργημένων μικροβίων, το 2010 ερευνητές συνέθεσαν ένα βακτηριακό γονιδίωμα και στη συνέχεια το μεταμόσχευσαν σε ένα ζωντανό κύτταρο, δημιουργώντας αυτό που ονόμασαν το πρώτο συνθετικό κύτταρο.
Ωστόσο, υπήρχε ένα πρόβλημα. Ήταν πολύ δύσκολο να είμαστε σίγουροι αν το κύτταρο κυβερνούταν πραγματικά από το συνθετικό γονιδίωμα και όχι από το αρχικό του, επειδή τα βακτήρια συχνά απορροφούν γενετικό υλικό από το περιβάλλον και το προσθέτουν στα δικά τους γονιδιώματα σε μια διαδικασία που ονομάζεται οριζόντια μεταφορά γονιδίων.
Για να ξεπεράσουν αυτό το ζήτημα, ο John Glass στο J. Craig Venter Institute (JCVI) στην La Jolla της Καλιφόρνια, και οι συνεργάτες του αποφάσισαν να σκοτώσουν πρώτα το κύτταρο-ξενιστή – ή τουλάχιστον το γονιδίωμά του.
Οι ερευνητές στράφηκαν σε μια χημική ουσία που ονομάζεται μιτομυκίνη C, η οποία χρησιμοποιείται ως φάρμακο χημειοθεραπείας για τη θανάτωση καρκινικών κυττάρων καταστρέφοντας το DNA τους, και τη δοκίμασαν σε κύτταρα του απλού βακτηρίου Mycoplasma capricolum.
«Το κύτταρο είναι ακόμα υγιές, αλλά επειδή δεν μπορεί πλέον να αναπαραχθεί και το γονιδίωμα δεν λειτουργεί πλέον, είναι καταδικασμένο να πεθάνει ή είναι ήδη νεκρό», λέει η μέλος της ομάδας Zumra Seidel, επίσης στο JCVI.
Στη συνέχεια, πρόσθεσαν μια συνθετική έκδοση του γονιδιώματος ενός άλλου βακτηρίου, του Mycoplasma mycoides, στα νεκρά κύτταρα χρησιμοποιώντας μια τεχνική που ονομάζουν μεταμόσχευση ολόκληρου γονιδιώματος.
Ορισμένα από τα βακτήρια άρχισαν να αναπτύσσονται και να διαιρούνται κανονικά, και οι γενετικές δοκιμές έδειξαν ότι έφεραν το συνθετικό γονιδίωμα. Αυτό τα καθιστά τα πρώτα ζωντανά, συνθετικά βακτηριακά κύτταρα κατασκευασμένα από μη ζωντανά μέρη, υποστηρίζουν οι ερευνητές, οι οποίοι τα αποκαλούν «ζόμπι κύτταρα» επειδή έχουν αναβιώσει μετά τον θάνατο.
«Παίρνουμε ένα κύτταρο χωρίς γονιδίωμα και είναι λειτουργικά νεκρό. Αλλά προσθέτοντας ένα νέο γονιδίωμα, αυτό το κύτταρο ανασταίνεται», λέει ο Glass.
Η Kate Adamala στο Πανεπιστήμιο της Μινεσότα χαρακτηρίζει την εργασία ως τεχνική ανακάλυψη. «Τοποθετούν ένα φορτίο γονιδιώματος σε έναν μη ζωντανό δέκτη, οπότε δεν λαμβάνουν καμία βοήθεια από τους δικούς του μηχανισμούς επιδιόρθωσης του ξενιστή. Ουσιαστικά τον επανεκκίνησαν», λέει. «Είναι εκπληκτική δουλειά».
Επίσης, θολώνει τα όρια μεταξύ ζωής και μη ύπαρξης, λέει η Adamala. «Το επιχειρηματικό μοντέλο οποιουδήποτε σωστού ζωντανού κυττάρου είναι να μεταβολίζεται και να αναπαράγεται. Αυτές οι λειτουργίες έγιναν το σήμα κατατεθέν της ζωής. Το γονιδίωμα του δέκτη [κυττάρου] σε αυτό κάνει πολύ λίγο υπολειμματικό μεταβολισμό και σίγουρα δεν αναπαράγεται. Τι είναι τότε ένα αληθινό σήμα κατατεθέν της ζωής;»
Η μέλος της ομάδας Elizabeth Strychalski στο National Institute of Standards and Technology στο Gaithersburg του Maryland, προτείνει ότι η βιολογία μπορεί να λειτουργεί τακτικά σε ένα πορώδες όριο μεταξύ ζωής και θανάτου. «Ελπίζω αυτό να προκαλέσει στους ανθρώπους να σκεφτούν πώς η ζωή είναι μια σειρά από διαδικασίες και αν φέρουμε μια μηχανουργική νοοτροπία σε αυτό, μπορούμε να δούμε το ζωντανό μας σύστημα και να ρωτήσουμε ποιες διαδικασίες πραγματικά χρειαζόμαστε για τον τελικό στόχο που προσπαθούμε να επιτύχουμε».
Μέχρι στιγμής, η τεχνική έχει δοκιμαστεί μόνο σε Mycoplasma, αλλά η ομάδα την βλέπει ως απόδειξη της αρχής που θα μπορούσε να επιτρέψει ταχύτερη δημιουργία συνθετικών οργανισμών για να λειτουργούν ως μίνι εργοστάσια χημικών, παράγοντας θεραπευτικά φάρμακα ή εκτελώντας περιβαλλοντική αποκατάσταση.
«Για πολύ καιρό, είχαμε την ικανότητα να συναρμολογούμε πολύ μεγάλα κομμάτια συνθετικού DNA, αλλά δεν καταφέραμε να τα παραδώσουμε σε ένα μέρος όπου μπορούν να κάνουν χρήσιμα πράγματα», λέει η Strychalski. «Είναι σαν να έχεις ένα σενάριο για ένα έργο του Σαίξπηρ, αλλά να μην μπορείς πραγματικά να το ανεβάσεις».
Ο Akos Nyerges στο Harvard Medical School λέει ότι η εργασία αντιμετωπίζει μια μεγάλη πρόκληση στη συνθετική βιολογία. «Αυτή η τεχνολογία καθιστά τη μεταφορά γονιδιώματος μια πιο προβλέψιμη και αξιόπιστη στρατηγική, η οποία δυνητικά ανοίγει πολλές επακόλουθες εφαρμογές σε άλλα είδη», λέει.
Η μετάβαση σε πιο σύνθετους οργανισμούς όπως η μαγιά ή το E. coli μπορεί να είναι δύσκολη, επειδή αυτοί οι οργανισμοί έχουν κυτταρικό τοίχωμα, το οποίο το Mycoplasma στερείται, και μεγαλύτερα γονιδιώματα, αλλά ο Glass είναι αισιόδοξος ότι η τεχνική θα πετύχει και σε αυτά.
«Αν αυτό λειτουργεί για έναν τύπο οργανισμού, είναι πιθανό να λειτουργήσει και για έναν άλλο», λέει, και το εργαστήριό του διερευνά τρόπους αφαίρεσης και αντικατάστασης των κυτταρικών τοιχωμάτων. «Στις σωστές συνθήκες ανάπτυξης, το E. coli θα κάνει ένα νέο κυτταρικό τοίχωμα», λέει.
Υπάρχει πάντα η πιθανότητα προβλημάτων βιοασφάλειας με τη συνθετική βιολογία, λέει ο Nyerges. Τα είδη Mycoplasma που χρησιμοποιήθηκαν στη μελέτη είναι παθογόνα σε κατσίκες και βοοειδή, αλλά λέει ότι καμία από τις τροποποιήσεις δεν αναμένεται να αυξήσει τη λοιμογόνο δύναμη.
Η Strychalski λέει ότι οι υπάρχουσες εργαστηριακές βέλτιστες πρακτικές διασφαλίζουν ότι ο κίνδυνος διαφυγής παθογόνων είναι ελάχιστος.